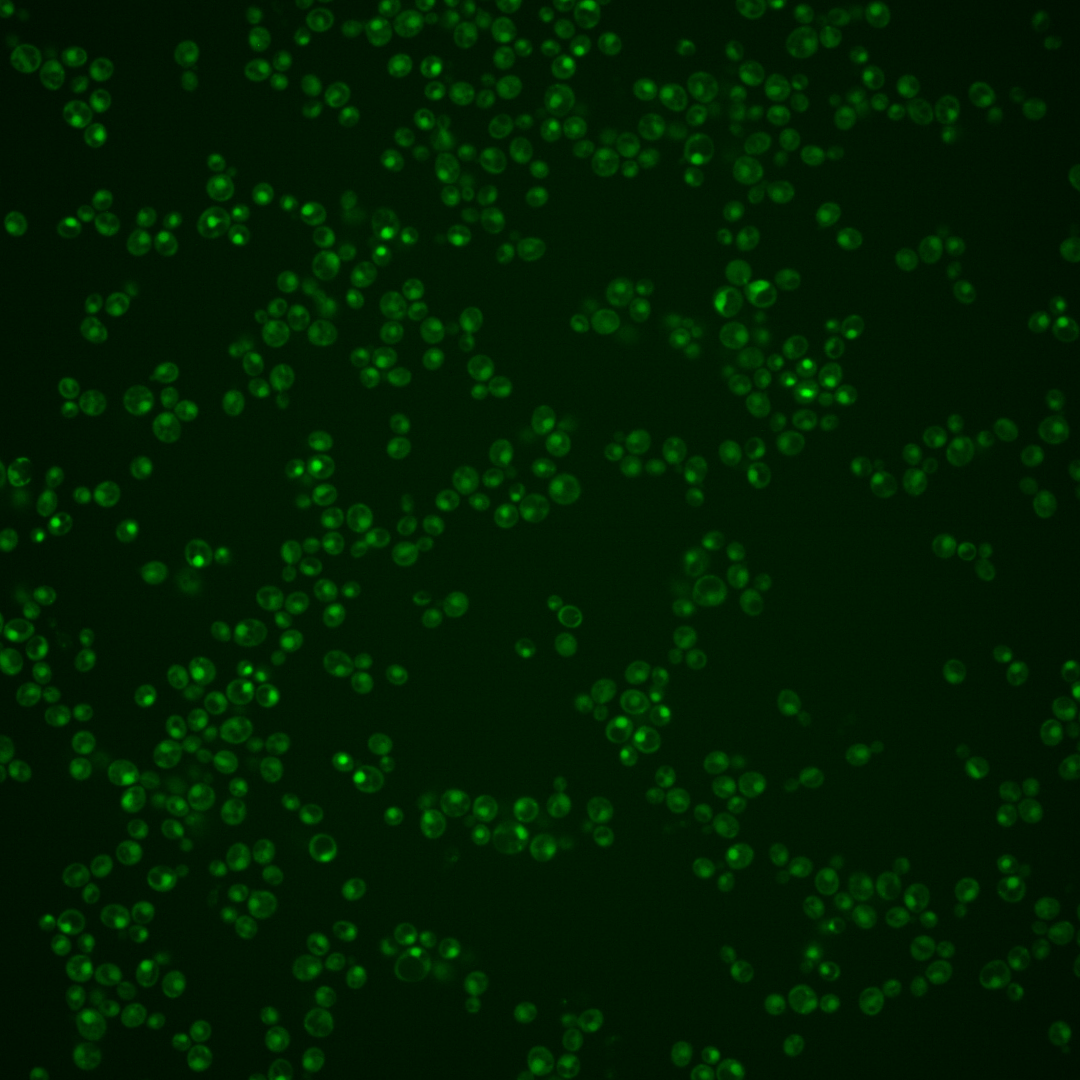
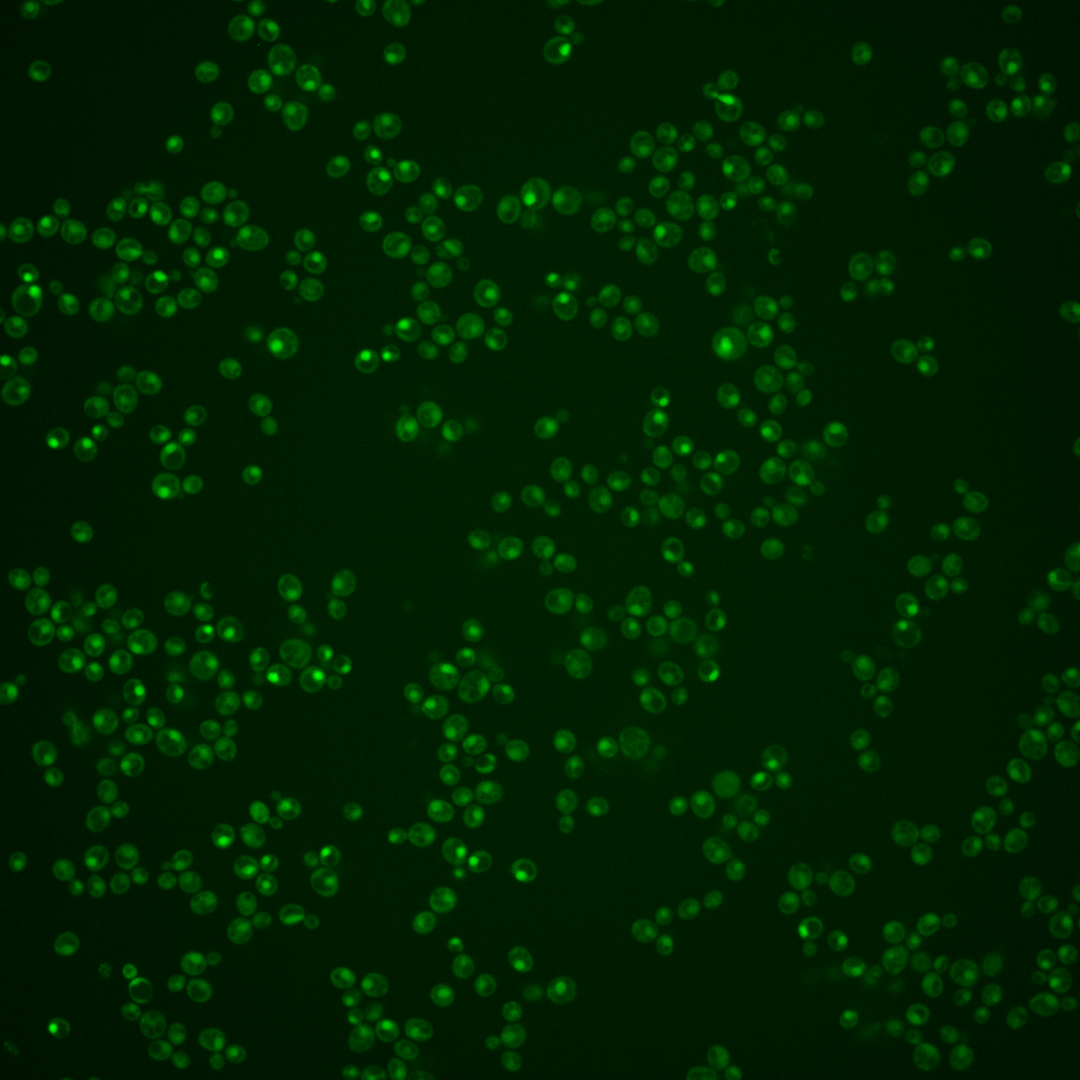

| Standard name | |
|---|---|
| Human Ortholog | |
| Description | Nuclear thiol peroxidase; functions as an alkyl-hydroperoxide reductase during post-diauxic growth |
Micrographs




















































































Sub-cellular Localization
Yeast GFP Assignment
Protein Abundance
Localization Change
External localization resources
| ensLOC | DeepLoc | |||||||||||||||||||||||
|---|---|---|---|---|---|---|---|---|---|---|---|---|---|---|---|---|---|---|---|---|---|---|---|---|
| Localization | WT1 | WT2 | WT3 | RAP60 | RAP140 | RAP220 | RAP300 | RAP380 | RAP460 | RAP540 | RAP620 | RAP700 | HU80 | HU120 | HU160 | rpd3Δ_1 | rpd3Δ_2 | rpd3Δ_3 | WT1 | WT2 | WT3 | AF100 | AF140 | AF180 |
| Cortical Patches | 0 | 0 | 0 | 0 | 0 | 0 | 0 | – | 0 | 0 | 0 | 0 | 0 | 0 | 0 | 0 | 0 | 0 | 1 | 1 | 1 | 1 | 1 | 1 |
| Bud | 0 | 1 | 0 | 0 | 0 | 1 | 2 | – | 5 | 3 | 3 | 2 | 0 | 1 | 0 | 0 | 0 | 0 | 1 | 3 | 2 | 2 | 9 | 6 |
| Bud Neck | 0 | 0 | 0 | 0 | 0 | 0 | 0 | – | 1 | 0 | 2 | 2 | 0 | 0 | 0 | 0 | 0 | 0 | 0 | 0 | 0 | 0 | 1 | 0 |
| Bud Site | 0 | 0 | 0 | 0 | 0 | 12 | 1 | – | 17 | 9 | 20 | 21 | 0 | 0 | 0 | 0 | 0 | 0 | – | – | – | – | – | – |
| Cell Periphery | 0 | 0 | 0 | 0 | 0 | 0 | 1 | – | 0 | 0 | 0 | 0 | 0 | 0 | 0 | 0 | 0 | 0 | 0 | 0 | 0 | 0 | 0 | 0 |
| Cytoplasm | 11 | 12 | 19 | 37 | 26 | 29 | 29 | – | 15 | 18 | 9 | 23 | 17 | 43 | 60 | 19 | 14 | 13 | 4 | 3 | 5 | 3 | 4 | 9 |
| Endoplasmic Reticulum | 0 | 0 | 0 | 0 | 0 | 0 | 0 | – | 0 | 0 | 1 | 0 | 0 | 0 | 0 | 2 | 3 | 0 | 0 | 0 | 0 | 0 | 1 | 2 |
| Endosome | 0 | 3 | 0 | 5 | 1 | 0 | 1 | – | 0 | 3 | 0 | 0 | 0 | 1 | 2 | 0 | 1 | 0 | 5 | 0 | 0 | 1 | 1 | 4 |
| Golgi | 0 | 1 | 1 | 0 | 1 | 0 | 0 | – | 0 | 0 | 0 | 0 | 0 | 0 | 0 | 0 | 0 | 1 | 0 | 2 | 1 | 0 | 1 | 1 |
| Mitochondria | 9 | 17 | 2 | 12 | 2 | 51 | 16 | – | 55 | 31 | 66 | 69 | 3 | 0 | 1 | 3 | 3 | 6 | 2 | 0 | 1 | 2 | 5 | 3 |
| Nucleus | 181 | 134 | 203 | 262 | 294 | 263 | 443 | – | 353 | 407 | 306 | 371 | 158 | 240 | 229 | 121 | 105 | 116 | 196 | 135 | 206 | 106 | 210 | 206 |
| Nuclear Periphery | 1 | 0 | 1 | 5 | 15 | 4 | 8 | – | 8 | 14 | 3 | 3 | 0 | 0 | 1 | 0 | 0 | 0 | 0 | 0 | 0 | 0 | 0 | 1 |
| Nucleolus | 1 | 2 | 1 | 0 | 8 | 16 | 15 | – | 55 | 38 | 41 | 51 | 0 | 1 | 6 | 1 | 2 | 3 | 0 | 0 | 0 | 2 | 13 | 14 |
| Peroxisomes | 0 | 0 | 0 | 0 | 0 | 0 | 1 | – | 1 | 1 | 0 | 0 | 0 | 1 | 2 | 0 | 0 | 1 | 0 | 0 | 1 | 0 | 0 | 0 |
| SpindlePole | 1 | 0 | 4 | 8 | 5 | 1 | 3 | – | 1 | 5 | 1 | 8 | 0 | 0 | 4 | 0 | 0 | 1 | 2 | 2 | 4 | 2 | 9 | 11 |
| Vac/Vac Membrane | 23 | 24 | 7 | 10 | 13 | 10 | 11 | – | 2 | 12 | 6 | 2 | 3 | 9 | 14 | 5 | 8 | 6 | 17 | 16 | 21 | 29 | 56 | 48 |
| Unique Cell Count | 216 | 165 | 230 | 316 | 345 | 326 | 504 | 415 | 480 | 371 | 458 | 177 | 293 | 300 | 144 | 126 | 140 | 235 | 170 | 252 | 155 | 322 | 318 | |
| Labelled Cell Count | 227 | 194 | 238 | 339 | 365 | 387 | 531 | 513 | 541 | 458 | 552 | 181 | 296 | 319 | 151 | 136 | 147 | 235 | 170 | 252 | 155 | 322 | 318 | |
Yeast GFP Assignment
Protein Abundance
| Screen | WT1 | WT2 | WT3 | RAP60 | RAP140 | RAP220 | RAP300 | RAP380 | RAP460 | RAP540 | RAP620 | RAP700 | HU80 | HU120 | HU160 | rpd3Δ_1 | rpd3Δ_2 | rpd3Δ_3 | AF100 | AF140 | AF180 |
|---|---|---|---|---|---|---|---|---|---|---|---|---|---|---|---|---|---|---|---|---|---|
| Mean Cell GFP Intensity (1e-4) | 5.0 | 5.5 | 6.3 | 6.6 | 7.8 | 6.0 | 7.2 | – | 6.3 | 7.2 | 6.1 | 6.1 | 6.3 | 6.8 | 7.0 | 8.5 | 8.9 | 9.0 | 5.7 | 6.2 | 6.9 |
| Std Deviation (1e-4) | 0.9 | 1.5 | 1.9 | 2.0 | 2.2 | 2.2 | 1.9 | – | 1.7 | 2.2 | 1.9 | 1.7 | 1.7 | 2.0 | 2.0 | 2.9 | 2.5 | 2.8 | 2.0 | 1.9 | 2.8 |
| Intensity Change (Log2) | – | – | – | 0.05 | 0.3 | -0.08 | 0.18 | – | -0.0 | 0.18 | -0.06 | -0.05 | -0.01 | 0.1 | 0.14 | 0.43 | 0.49 | 0.51 | -0.16 | -0.04 | 0.13 |
Localization Change
| Localization | RAP60 | RAP140 | RAP220 | RAP300 | RAP380 | RAP460 | RAP540 | RAP620 | RAP700 | HU80 | HU120 | HU160 | rpd3Δ_1 | rpd3Δ_2 | rpd3Δ_3 |
|---|---|---|---|---|---|---|---|---|---|---|---|---|---|---|---|
| Cortical Patches | 0 | 0 | 0 | 0 | – | 0 | 0 | 0 | 0 | 0 | 0 | 0 | 0 | 0 | 0 |
| Bud | 0 | 0 | 0 | 0 | – | 0 | 0 | 0 | 0 | 0 | 0 | 0 | 0 | 0 | 0 |
| Bud Neck | 0 | 0 | 0 | 0 | – | 0 | 0 | 0 | 0 | 0 | 0 | 0 | 0 | 0 | 0 |
| Bud Site | 0 | 0 | 0 | 0 | – | 3.1 | 0 | 3.6 | 3.3 | 0 | 0 | 0 | 0 | 0 | 0 |
| Cell Periphery | 0 | 0 | 0 | 0 | – | 0 | 0 | 0 | 0 | 0 | 0 | 0 | 0 | 0 | 0 |
| Cytoplasm | 1.3 | -0.3 | 0.3 | -1.3 | – | -2.5 | -2.5 | -3.3 | -1.7 | 0.5 | 2.3 | 3.8 | 1.5 | 0.9 | 0.3 |
| Endoplasmic Reticulum | 0 | 0 | 0 | 0 | – | 0 | 0 | 0 | 0 | 0 | 0 | 0 | 0 | 0 | 0 |
| Endosome | 0 | 0 | 0 | 0 | – | 0 | 0 | 0 | 0 | 0 | 0 | 0 | 0 | 0 | 0 |
| Golgi | 0 | 0 | 0 | 0 | – | 0 | 0 | 0 | 0 | 0 | 0 | 0 | 0 | 0 | 0 |
| Mitochondria | 2.1 | 0 | 5.8 | 1.9 | – | 5.3 | 3.3 | 6.4 | 5.8 | 0 | 0 | 0 | 0 | 0 | 0 |
| Nucleus | -1.7 | -1.0 | -2.4 | -0.1 | – | -1.1 | -1.2 | -1.9 | -2.4 | 0.3 | -2.0 | -3.5 | -1.2 | -1.3 | -1.5 |
| Nuclear Periphery | 0 | 2.8 | 0 | 0 | – | 0 | 0 | 0 | 0 | 0 | 0 | 0 | 0 | 0 | 0 |
| Nucleolus | 0 | 0 | 3.0 | 2.2 | – | 5.5 | 4.1 | 5.0 | 5.0 | 0 | 0 | 0 | 0 | 0 | 0 |
| Peroxisomes | 0 | 0 | 0 | 0 | – | 0 | 0 | 0 | 0 | 0 | 0 | 0 | 0 | 0 | 0 |
| SpindlePole | 0.6 | 0 | 0 | 0 | – | 0 | 0 | 0 | 0 | 0 | 0 | 0 | 0 | 0 | 0 |
| Vacuole | 0.1 | 0.5 | 0 | -0.7 | – | 0 | -0.4 | 0 | 0 | 0 | 0 | 0.9 | 0 | 1.5 | 0 |
External localization resources
Images






























Protein Concentration and Protein Localization Data
| R1 | R2 | R3 | ||||||||||||||||
|---|---|---|---|---|---|---|---|---|---|---|---|---|---|---|---|---|---|---|
| G1 Pre-START | G1 Post-START | S/G2 | Metaphase | Anaphase | Telophase | G1 Pre-START | G1 Post-START | S/G2 | Metaphase | Anaphase | Telophase | G1 Pre-START | G1 Post-START | S/G2 | Metaphase | Anaphase | Telophase | |
| Concentration | -0.4787 | -0.2525 | -0.3616 | -0.8535 | -0.9824 | -0.8784 | 2.5812 | 1.7689 | 1.5923 | 1.5384 | 1.4861 | 1.7457 | 4.363 | 3.7356 | 4.1867 | 3.9781 | 3.873 | 4.1002 |
| Actin | 0.0535 | 0 | 0.0007 | 0 | 0.0045 | 0.0003 | 0.0761 | 0.002 | 0.0029 | 0.0021 | 0.0002 | 0.0038 | 0.0385 | 0 | 0 | 0 | 0 | 0.0001 |
| Bud | 0.0005 | 0.0001 | 0.0001 | 0 | 0.0002 | 0 | 0.0005 | 0.0003 | 0.0001 | 0 | 0 | 0 | 0.0002 | 0 | 0 | 0 | 0 | 0 |
| Bud Neck | 0.0009 | 0.0002 | 0.0006 | 0.0002 | 0.0008 | 0.0013 | 0.0027 | 0.0014 | 0.0003 | 0.0001 | 0.0004 | 0.0013 | 0.0028 | 0.0001 | 0.0001 | 0.0001 | 0.0002 | 0.0009 |
| Bud Periphery | 0.0007 | 0.0001 | 0.0001 | 0 | 0.0002 | 0.0001 | 0.0011 | 0.0005 | 0.0001 | 0 | 0.0001 | 0.0001 | 0.0002 | 0 | 0 | 0 | 0 | 0 |
| Bud Site | 0.002 | 0.0003 | 0.0004 | 0 | 0.0005 | 0.0001 | 0.0013 | 0.0013 | 0.0002 | 0.0001 | 0.0002 | 0.0001 | 0.0007 | 0.0001 | 0 | 0 | 0.0001 | 0.0001 |
| Cell Periphery | 0.0002 | 0 | 0 | 0 | 0.0001 | 0 | 0.0002 | 0.0001 | 0 | 0 | 0 | 0 | 0.0001 | 0 | 0 | 0 | 0 | 0 |
| Cytoplasm | 0.0162 | 0.0141 | 0.0209 | 0.0223 | 0.0245 | 0.0068 | 0.0097 | 0.0087 | 0.0055 | 0.0006 | 0.0009 | 0.0005 | 0.0058 | 0.0146 | 0.0031 | 0.0023 | 0.0011 | 0.006 |
| Cytoplasmic Foci | 0.0191 | 0.0032 | 0.0125 | 0.0002 | 0.012 | 0.001 | 0.0124 | 0.0002 | 0.0023 | 0.0026 | 0.0031 | 0.0011 | 0.0046 | 0.0002 | 0 | 0 | 0 | 0.0004 |
| Eisosomes | 0.0003 | 0 | 0 | 0 | 0 | 0 | 0.0005 | 0 | 0.0001 | 0 | 0 | 0 | 0.0003 | 0 | 0 | 0 | 0 | 0.0001 |
| Endoplasmic Reticulum | 0.0017 | 0.0006 | 0.0015 | 0.0002 | 0.0017 | 0.0002 | 0.0049 | 0.0009 | 0.0004 | 0.0002 | 0.0001 | 0.0006 | 0.005 | 0.0004 | 0.0001 | 0 | 0 | 0.0005 |
| Endosome | 0.0283 | 0.0089 | 0.0091 | 0.0001 | 0.0646 | 0.0002 | 0.0253 | 0.0014 | 0.0044 | 0.0051 | 0.0031 | 0.0028 | 0.01 | 0.0005 | 0 | 0 | 0 | 0.0004 |
| Golgi | 0.0139 | 0.0002 | 0.0043 | 0 | 0.071 | 0 | 0.0106 | 0.0003 | 0.0016 | 0.0051 | 0.0014 | 0.0016 | 0.0027 | 0 | 0 | 0 | 0 | 0 |
| Lipid Particles | 0.0352 | 0.0001 | 0.0039 | 0 | 0.0049 | 0.0002 | 0.0174 | 0.0005 | 0.0023 | 0.0159 | 0.0139 | 0.0083 | 0.0034 | 0 | 0 | 0 | 0 | 0.0001 |
| Mitochondria | 0.0212 | 0.0005 | 0.0007 | 0.0001 | 0.0075 | 0.0001 | 0.0069 | 0.0005 | 0.0037 | 0.0006 | 0.0008 | 0.0029 | 0.0007 | 0.0002 | 0.0001 | 0.0001 | 0.0002 | 0.0001 |
| None | 0.0133 | 0.0044 | 0.0488 | 0.0613 | 0.0061 | 0.0479 | 0.0094 | 0.0115 | 0.0173 | 0.0002 | 0.0004 | 0.0089 | 0.0087 | 0.0096 | 0.0197 | 0.0027 | 0.0003 | 0.0283 |
| Nuclear Periphery | 0.0116 | 0.0078 | 0.0151 | 0.0048 | 0.0434 | 0.0064 | 0.0318 | 0.0123 | 0.004 | 0.0008 | 0.0026 | 0.0083 | 0.0117 | 0.0066 | 0.0018 | 0.001 | 0.0046 | 0.0024 |
| Nucleolus | 0.0059 | 0.0065 | 0.0039 | 0.0027 | 0.0044 | 0.0088 | 0.0055 | 0.015 | 0.0036 | 0.0042 | 0.0268 | 0.0132 | 0.0035 | 0.0049 | 0.0031 | 0.0031 | 0.0068 | 0.0139 |
| Nucleus | 0.7462 | 0.9468 | 0.8695 | 0.904 | 0.7422 | 0.8896 | 0.7506 | 0.9254 | 0.9377 | 0.9386 | 0.9243 | 0.9315 | 0.8818 | 0.9526 | 0.9706 | 0.988 | 0.9806 | 0.9129 |
| Peroxisomes | 0.0119 | 0 | 0.0019 | 0 | 0.0012 | 0 | 0.0115 | 0.0001 | 0.0013 | 0.002 | 0.0145 | 0.0095 | 0.0092 | 0 | 0 | 0 | 0 | 0 |
| Punctate Nuclear | 0.013 | 0.003 | 0.0048 | 0.0038 | 0.0064 | 0.0365 | 0.0172 | 0.0162 | 0.0112 | 0.0215 | 0.0068 | 0.005 | 0.0091 | 0.0098 | 0.0012 | 0.0025 | 0.0059 | 0.0334 |
| Vacuole | 0.0029 | 0.0026 | 0.0009 | 0.0001 | 0.0022 | 0.0003 | 0.0018 | 0.0011 | 0.0008 | 0.0001 | 0.0003 | 0.0002 | 0.0005 | 0.0003 | 0.0001 | 0.0001 | 0.0001 | 0.0003 |
| Vacuole Periphery | 0.0017 | 0.0006 | 0.0004 | 0 | 0.0015 | 0.0001 | 0.0027 | 0.0003 | 0.0003 | 0.0001 | 0.0001 | 0.0003 | 0.0004 | 0.0001 | 0 | 0 | 0 | 0.0001 |
Sequencing Data
| R1 | R2 | |||||||||
|---|---|---|---|---|---|---|---|---|---|---|
| G1 Post-START | S/G2 | Metaphase | Anaphase | Telophase | G1 Post-START | S/G2 | Metaphase | Anaphase | Telophase | |
| Gene Expression | 40.0154 | 42.6212 | 33.8858 | 41.0752 | 34.2199 | 45.9497 | 46.9419 | 47.2643 | 55.8499 | 50.696 |
| Translational Efficiency | 2.6257 | 1.5762 | 1.8247 | 1.8968 | 1.9892 | 2.7954 | 1.8235 | 1.7701 | 1.7413 | 1.6269 |
Hit Data
| Dataset | Hit |
|---|---|
| Protein Concentration | ✘ |
| Protein Localization | ✘ |
| Gene Expression | ✘ |
| Translational Efficiency | ✘ |
Endocytosis
| Temp | Actin Patch (Sac6-tdTomato) | Cortical Patch (Sla1-GFP) | Late Endosome (Snf7-GFP) | Vacuole (Vph1-GFP) |
|---|---|---|---|---|
| 37℃ | ||||
| RT |
Cell Cycle Omics
CYCLoPs (Dot5-GFP)
| Gene / Allele | Actin Patch (Sac6-tdTomato) | Cortical Patch (Sla1-GFP) | Late Endosome (Snf7-GFP) | Vacuole (Sac6-tdTomato) |
|---|
| Gene | Images |
|---|
| Gene | Images |
|---|
Images are not yet available
Images are not yet available